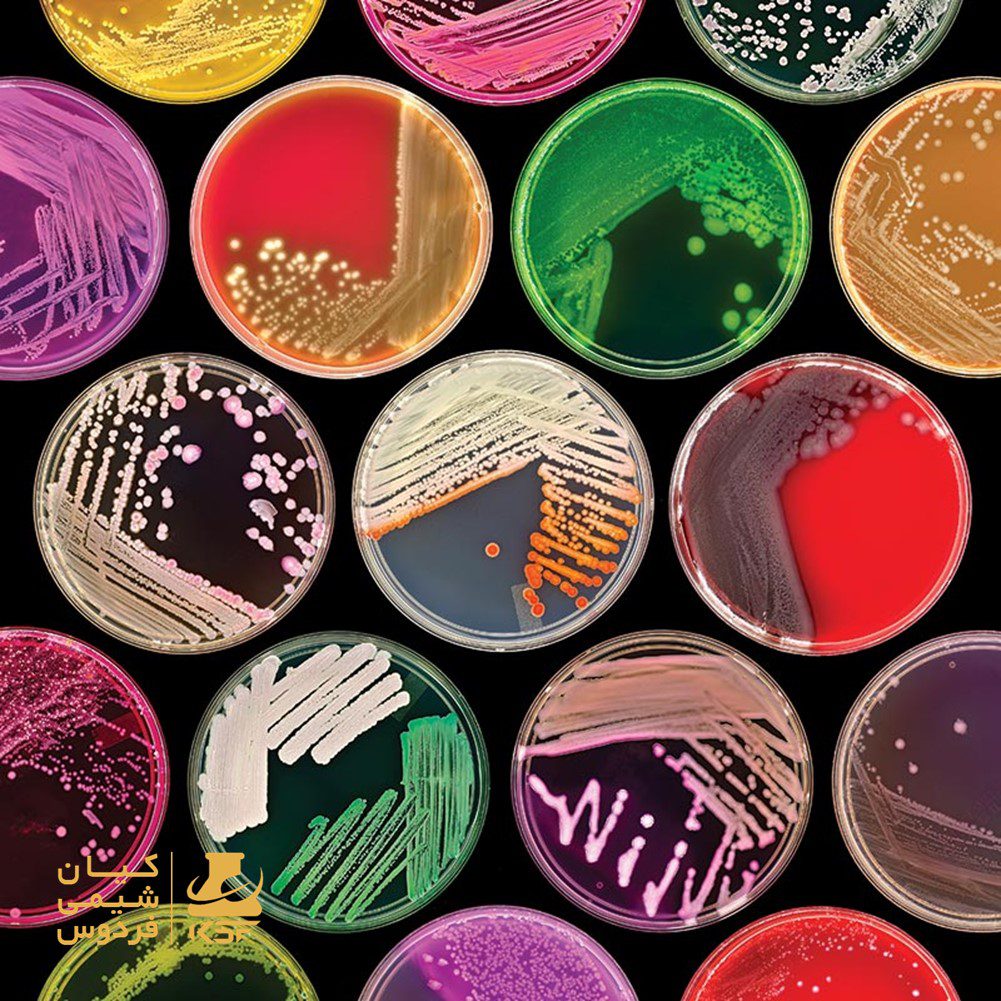
معرفی محیط کشت و انواع آن

محیط کشت چیست؟
محیط کشت چیست؟ معرفی محیط کشت و انواع آن محیط کشت به مخلوطی از مواد غذایی و شیمیایی گفته میشود که برای رشد و پرورش میکروارگانیسمها، گیاهان، یا سلولها در آزمایشگاهها یا مراکز تحقیقاتی طراحی شده است. این محیطها میتوانند بهطور خاص برای نیازهای جانداران مختلف تنظیم شوند تا بهترین شرایط رشد و توسعه را […]
مرک چیست؟

شرکت مرک در صنایع شیمیایی، داروسازی و صنایع الکترونیک فعالیت میکند، برند مرک جزو یکی از بزرگترین و قدیمی ترین شرکتهای شیمیایی و دارویی در جهان است و به طور سالیانه حدود 35.4 میلیارد دلار فروش دارد و چهارمین شرکت بزرگ دارویی در جهان است و یک شرکت چند ملیتی آلمانی میباشد. دفتر […]
